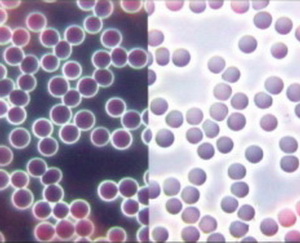

Symbionty, naše soukromé vojsko
Bavíme se o stavbě nových základů a začnu proto trochu z jiného soudku, pro snadnější pochopení logiky našeho zdraví, života i smrti. Po absolvování studia jsem byl jako rebel, za odměnu, umístěn do základní vojenské služby k pracovnímu útvaru, jednotky byly známé jako PTP pomocné technické prapory. Tak mě napadlo přirovnání, že naše zdraví funguje na velice podobném principu. Tyto jednotky měly jako bojový úkol budovat, nebo odstraňovat nejrůznější stavby, od železnice, přes silnice až k běžné výstavbě domů. Měly jednotné velení s nedílnou rozhodovací pravomocí a od generála po posledního vojáka, každý dodržoval interní předpisy, nazveme je zákon. Každý měl svůj úkol a ten bez reptání, nebo s reptáním plnil. Celé to dění, bylo relativně dobře organizované a prováděné práce probíhaly mnohem rychleji, než v běžném stavebnictví, kde organizace vázla díky tomu, že zde každý mohl dělat to, co chtěl. Aby každý poslouchal, systém měl k tomu pochvaly a odměny i řadu kázeňských trestů pro nejrůznější pochybení. Stupnice zahrnovala drobné, větší i velké tresty a v extrémním případě i trest smrti. Asi se nyní divíte, proč píšu na stránkách o zdraví o vojenském stavebním vojsku, ale nebojte se je tu veliká podobnost. Naše tělo má v sobě také takové velice dobře organizované stavební jednotky, které se nazývají symbionty. Symbionti jsou nejinteligentnější, nejdisciplinovanější a nejpracovitější armáda, kterou znám s naprosto dokonalým velením a zákonem. Symbionti se nám starají o výstavbu a údržbu, nebo bourání tkání, orgánů i těla. Jde o stavební armádu mnohem lépe organizovanou, než byla ta v níž jsem sloužil a dodržuje i mnohem striktněji zákon postavený generálním velitelem Matkou přírodou. Tento velitel striktně vyžaduje perfektní plnění přírodního zákona, za což nás odměňuje zdravím a každé nepatrné přestupky nekompromisně trestá nemocemi. Je tvrdý, ale spravedlivý a jeho zákony platí i pro horních 10 000, připusťme velitelský sbor. V civilním životě sem patří státníci, politici, úředníci složek státní správy a samozřejmě i lékaři, ani u nich kupodivu nedělá výjimky, neuznává kompromisy a přiděluje odměny i kázeňské tresty za pochybení každému zcela bez rozdílu, ať jsi pán, nebo kmán. Jako limitující rozkaz pro výstavbu, nebo bourání našeho těla symbionti uznávají pH tělních tekutin, což je zákon postavený velitelem Matkou přírodou. Správné pH buď dodržíme a probíhá výstavba i údržba těla, vlastně jsme odměněni perfektním zdravím a spokojeným životem, nebo to nedodržíme a následuje trest v podobě bourání a rozebírání našeho těla. Za malé pochybení je to drobný neduh, ze kterého se snadno dostaneme, po delší době porušování zákona je trest tvrdší, až velmi tvrdý a pokud chceme rebelovat stále nezbývá veliteli Matce přírodě jiné řešení, než udělit trest nejvyšší, trest smrti. Velitel Matka příroda je spravedlivý, tvrdý a jeho zákon je na rozdíl od těch lidských velice pevný a neměnný. Nyní si tedy o této naší vlastní armádě popovídáme detailně.
©
Věčný cyklus

Veškerá hmota, včetně všeho živého, se skládá z atomů. Všechny atomy sestávají ze tří druhů „částic“: protonů, neutronů a elektronů. Protony a neutrony jsou shromážděny pohromadě v centru atomu – v jeho „jádru“ (představme si „jádro“ jako Slunce a Merkur). Elektrony rychle kroužící na vzdálenějších oběžných drahách okolo (ekvivalentních odstupů Pluta) formují kolem „jádra“ jakousi „slupku“, uzavírající „sluneční soustavu“ atomu. Rychlý pohyb elektronu okolo jádra produkuje elektrický tok, jenž na oplátku vyvolává elektromagnetizmus. Avšak toto je jen jeden zdroj magnetizmu atomu. Elektrony kromě orbitálního pohybu rotují kolem vlastní osy (jako naše Země) čímž vytvářejí vlastní magnetické pole. Protony a neutrony uvnitř jádra mají také vlastní oběh a rotaci, jen v menším prostoru, což má za následek magnetizmus jádra, i když se navenek projevuje mnohem slaběji, než magnetizmus vytvářený elektrony pohybujícími se vně. Celek se udržuje v neustálé rovnováze. Vektorový součet všech uvedených sil udává celkový elektromagnetický impuls atomu a určuje jeho charakteristický kmitočet. Mimo elektrony vázané na atomární struktury existují v mezi atomárním prostoru nevázané částice urychlované elektromagnetickými poli, jejichž střety s atomy vyvolávají ionizaci – tzv. „volné elektrony“. Počet protonů v jádru atomu prvku je určující pro jeho atomové číslo. Protony mají kladný náboj (+), neutrony nemají žádný a elektron je nosičem záporného náboje (-). Množství náboje v elektricky neutrálním atomu je zásluhou vzájemného působení protonů a elektronů vyrovnané. Máme zde ale zmíněné volné elektrony, pohybující se volně mezi atomy, s nimiž kolidují. Tyto srážky, v závislosti na rychlosti volných elektronů, vedou k obohacení nebo naopak ztrátám náboje elektronů tvořících vnější slupku atomu a tím i energie. Aktivované atomy s vetší, nebo menší energií elektronů ve svých slupkách se nazývají ionty. Jestliže nějaký atom po srážce s urychleným volným elektronem přijde o část energie elektronů ve své slupce (jako třeba v mikrovlnné troubě), získá kladný náboj (+), a protože v něm převažuje náboj uložený v protonech, snaží se dosáhnout rovnováhy odsáváním záporného náboje ze svého okolí. Takovému atomu říkáme kation. Jestliže atom naopak získá náboj nesený volným elektronem, převažuje u něj záporný náboj (-) a říkáme mu anion. Procesu, při němž dochází ke ztrátě, nebo zisku náboje elektronu v atomárním obalu, říkáme ionizace. Vybuzené atomy – ionty – se vůči svému okolí nacházejí v nerovnováze, která se navenek jeví jako elektrický potenciál (energie). Obsah volných elektronů v mezi atomárním prostoru a energie, již jsou pohybovány, (úroveň ionizace), určuje elektrické vlastnosti a chemickou reaktivitu atomu, a tím i elektrické a chemické vlastnosti veškeré hmoty.
SHRNUTÍ: Ionizace určuje elektrické a chemické vlastnosti hmoty.
Vodík je nejhojnějším prvkem ve vesmíru. Ve vazbě na kyslík vytváří polární molekulu známou jako voda, která je znamenitým rozpouštědlem a prostředím pro chemické reakce. Každá chemická reakce je tedy elektromagnetické povahy (ionizace). Všechny živé věci na této planetě obsahují velké množství vody – tělíčko novorozence z ní sestává z 90%, zdraví dospělí lidé jí mají v těle méně než 80%, staří mírně nad 60% a nemocní lidé asi 50%. Všechny existující substance přepravované, nebo chemicky měněné v živém organizmu, jsou rozpustné ve vodě a závislé na pH a teplotě. Všechny vodné roztoky mají vlastnost vyčíslitelnou hodnotou pH, představující relativní množství koncentrace protonu (iontu vodíku, H+) v roztoku; tento údaj tedy reprezentuje stupeň ionizace. Hodnota pH sahá od O na kyselém po 14 na alkalickém konci stupnice. Je-li jeho hodnota pH 7.0 je roztok považován za neutrální. Voda s pH 7.0 obsahuje vyrovnané koncentrace H+ a OH- iontů. Substance s pH menším než pH 7.0 jsou kyselé (+), protože obsahují vyšší koncentraci H+ iontů (jsou bohaté na protony). Substance s pH vyšším než pH 7.0 jsou alkalické (-), jelikož obsahují vyšší koncentraci OH- iontů (jsou bohaté na elektrony). Stupnice pH je logaritmická. To znamená, že změna o jeden stupeň (řekněme z pH6.0 na 7.0) představuje desetinásobnou změnu v počtu vodíkových iontů. Tyto pH vlastnosti mají enormní vliv na chemické reakce, při nichž jsou rozbíjeny staré a vznikají nové vazby (nová elektro-magnetická přeskupení způsobu, jímž jsou atomy spojeny dohromady), vznikají nové struktury s odlišnou identitou a nezvyklými kmitočty (kmitočet je signifikantní znak každého fyzikálního prvku), přenáší nezvyklou informaci o stavu uvnitř a vně těla. Každé onemocnění je v principu konflikt informací (vibrace je frekvence o jisté vlnové délce = informace) mezi různě uspořádanými atomy v nás. Zdravé tělo má celkovou vibraci okolo 68MHz, nemocné kmitá na 52MHz, rakovina se projevuje kmitočtem 42 MHz, a při 36MHz opouštíme tento svět.
SHRNUTÍ: Každá nepatrná změna pH vede k tvorbě nových chemických substancí s různými vibracemi. Čím vyšší vibrace, tím více životní síly.
Všechno co dýcháme, jíme a pijeme, zásobuje tělo živinami složenými z atomů. Tyto dodávky slouží buď k udržování správného pH našeho vnitřního prostředí, nebo k jeho změnám. Bohužel, naše tělo nemá žádnou jinou možnost než využít to, co spolykáme. To zpracovává a získává z toho výživu a elektrickou energii, aby mohlo 24 hodin denně budovat a čistit samo sebe. Každá organická buňka je elektrotechnické zařízení, které ze své podstaty musí mít dva póly (+/-) při specifické rovnováze a životní energii. Zdravá buňka má 70-90mV, nemocná 40-50mV a rakovinová buňka 15-20mV. Nebiologické stravovací návyky, psychologické faktory a imise, narušují bilanci kyselin a zásad (+/-) čímž se vnitřní tělesné prostředí mění buď na kyselejší, nebo alkaličtější. Veškerá uměle zpracovaná jídla a léčiva (kvůli způsobu přeuspořádání atomů při výrobě) mají všechny živiny a popele obsahující pozitivně nabité částice bohaté na protony(+) a nízkým obsahem elektronů(-), jsou tedy kyselé, s oscilací nula MHz, a tudíž nám odsávají energii. Všechny živiny a popele, pocházející ze živých (syrových) potravin poskytovaných přímo Matkou přírodou, mají záporně nabité částice bohaté na elektrony(-) s málo protony(+), jsou tudíž alkalické, s oscilací 15MHz a výše nám poskytují energii. Pokud jíme hlavně umělé produkty bohaté na protony, vnitřní tělesné prostředí (původně s převahou elektronů) se bude postupně měnit na prostředí bohaté na protony s kladným nábojem, tedy kyselé. V na protony(+) bohatém vnitřním prostředí počet elektronů(-) klesá a s ním i elektrický potenciál (naše energie se snižuje) a metabolické procesy se zpomalí. Ve vnitřním prostředí bohatém na elektrony (-), je tento efekt přesně opačný. Pokud se naše vnitřní prostředí posune z rozsahu pH podporujícího život (pH krve 7,35 > 7,45) jeho atomová, molekulární, buněčná, biologická a elektrická struktura se změní. Stane se z nás jiná bytost s jinou celkovou vibrací, odlišným myšlením, nezvyklým chováním, atd., čili začnou se s námi dít neobvyklé věci.
SHRNUTÍ: Protony (kyseliny) vyvolají nedostatek kyslíku a donutí buňky přepnout na anaerobní látkovou výměnu.
Krev je z 93% voda, která slouží jako médium pro chemické reakce, dopravuje kyslík a živiny ke všem buňkám (žijícím ve vodě) našeho těla. Červené krvinky a všechny živiny jsou neseny v krvi jako suspendované částice nazývané koloidy. Částice se souhlasnými náboji se navzájem odpuzují, zatímco částice s rozdílnými náboji se navzájem přitahují. Tento elektrokinetický fenomén, známý jako Zeta potenciál, je plně ovlivnitelný změnami pH. Jestliže v sobě máme více protonů (+) než elektronů (-), je hladina naší elektrické energie nízká a efekt odpuzování a přitahování nefunguje. V důsledku toho se červené krvinky, živiny a minerály z koloidní suspenze vytratí, vytvářejí se sraženiny a shluky. Tento jev, konverze kapaliny na tuhou látku, je viditelný v mikroskopu s temným polem, když pozorujeme živou krev nemocných obsahující dlouhé řetízky, či hustá seskupeni slepených červených krvinek, které se téměř nepohybují. Úroveň srážení pozorovaná v živé krvi může být v lymfatické tekutině až 10 krát horší. Šedesát procent lymfatického systému máme ve střevech, 20% kolem páteře a 20% na různých místech v těle. Úhrnně obsahuje třikrát více tekutiny, než krev. Když lymfatická tekutina zhoustne hnilobnými proteiny, už nemůže přebírat různé odpady z krve. V důsledku toho se hustota krve zvyšuje a schopnost červených krvinek dopravovat živiny a kyslík se prudce sníží, čímž překyselení a toxicita stále roste. Nemocniční pacienti, umírající na poslední stupeň rakoviny, mají rozpadlou krev a konzistence jejich lymfatické tekutiny nemá daleko k zubní pastě.

Toto je zdravá krev
(vlevo je záběr mikroskopu s temným polem, vpravo je se světlým polem)
Takhle vypadá naše krev, když nás zdravíčko opouští


Krev na začátku rakoviny, krvinky se slepují.
Krev ve třetím stupni rakoviny, krvinky mizí.
SHRNUTÍ: Protony kondenzují a vážou, zatím co elektrony oddělují a rozptylují.
Účinky změn pH jsou ovšem mnohem dalekosáhlejší, než jsme dosud uvedli. Přes více než 150 let víme, že každá buňka a tekutina z libovolné živé věci (od bakterií až po nás) obsahuje droboulinké, světélkující a velmi pohyblivé částice. Lékařští experti trvají na tom, že je to jen nepotřebná drť. Avšak soukromě financovaný mezinárodní výzkum v posledních 25 letech vynesl na světlo dne další poznatky, odhalující mnohé. Tyto malinké světélkující částice jsou naši užiteční symbionti. Jsou ohromně důležití pro život – kontrolují růst, dělení, diferencování a funkce buněk, dohlížejí na DNK/RNA, dezintegrují odumřelé, nebo mutované buňky (u každého z nás se objeví několik set rakovinových buněk denně), imobilizují narušitele, odbourávají teoreticky možné patogeny, štěpí jedovaté látky a různý odpad, které jsou vedlejšími produkty látkové výměny každé živé bytosti. Výsledky tohoto čištění jsou z těla vyháněny přes vyměšovací orgány – střeva, ledviny, průdušky a pleť. Symbionti tvoří nejsilnější základ našeho organizačního a primárního imunitního systému. Po letech pozorování a zkoumání jejich role se ví, že tito symbionti jsou VELMI citliví na změny pH tělesných tekutin, a že každá živá bytost zůstává zdravá a živá tak dlouho, dokud pH jejího vnitřního prostředí (coby hostitele symbiontů), podporuje potřeby těchto velmi užitečných světélkujících částic. Jen když je pH v život podporujícím rozsahu (tělesné tekutiny 6.4-6.8 a krev 7.35-7.45), nás organizují, čistí a budují. Je-li však pH tělesných tekutin a tkaní velmi nízké ( 5.0 a níže ), symbionti se velmi rychle změní v patogeny a začnou nás rozebírat na atomy.

Krev v pozdním čtvrtém stupni rakoviny, fibrin a plísně, krvinky prakticky neexistují.


Vnitřek nádoru pořízený elektronickým mikroskopem. Vpravo je přiblížen.
Plísně a plísně kam se podíváte!!!!
- přítomní v každé živé věci ve skutečné symbióze zajištující vzájemný prospěch
- jsou rostlinného původu, krystaličtí, nezničitelní a nesmrtelní
- nejmenší žijící inteligentní bytosti
- výchozím bodem, v němž se konkretizuje univerzální inteligentní energie do inteligentní hmoty
- primárním organizačním a čisticím prvkem uvnitř všech živých věcí
- zprostředkovateli přetvářející fotonovou energii slunečního světla na životní energii
- schopni přenášet ve fotonech obsažené plány pro život pomocí DNK/RNK,
- vytvářet, udržovat a vyživovat život
- ve své původní světélkující formě NIKDY nevyvolají žádné onemocnění hostitele
- v přímé odezvě na změny pH tělesných tekutin a vnitřního systémového prostředí hostitele jsou však schopni změnit své formy & funkce (pleomorfizmus)
Máme-li v těle správné vnitřní prostředí se zásaditým pH, symbionti náš vnitřní terén pilně udržují čistý a všechny procesy plně funkční. Když však naše tělo začne být kyselé a toxické, symbionti se přizpůsobí novému prostředí. Každá rozkládající se organická hmota má kyselé systémové prostředí (bohaté na protony) s nízkým obsahem kyslíku a v buňkách již probíhá anaerobní látková výměna. Převaha protonů je pro symbionty signálem oznamujícím, že jejich hostitel bude zakrátko technicky mrtvý, a proto se adaptují (stejně jako předtím tělesné buňky). Tato změna probíhá v rámci úplně přirozeného, normálního a předvídatelného cyklu v 13 krocích – ze symbionta na virus, pak přes bakterie až k plísním. Poslední forma vylučuje silné enzymy rozkládající kyselou organickou hmotu a shromažďuje ji do nejslabšího místa těla, kde vytvoří „smetiště“ které pečlivě zapouzdří, což my zveme „tumor“. Tato jejich akce nám prodlouží život po nějaký čas. Je-li však v těle stále mnoho kyselé organické hmoty a toxicity, plíseň vzniklé produkty vstřebává, přetváří a buduje další a další smetiště, která opět pečlivě zapouzdří. Úplný 13¬stupňový cyklus, v jehož průběhu se tyto organizmy exponenciálně zmnohonásobují (z milionů na miliardy), trvá jen 90 hodin. Avšak ještě než k tomu dojde, naše tělo vysílá navenek odlišné vibrace vlivem změněných sloučenin vznikajících poklesem pH a teploty. V důsledku tohoto cyklu se rapidně mění celé naše vibrační spektrum a nyní, aniž to víme, vysíláme pozvánku vnějším patogenům, aby se v nás usadily a pomohly při sběru kyselosti umírající organické hmoty. Mezitím hostitel spoléhá na lékaře a pilně polyká pilulky v domnění, že si zlepšuje zdraví. Přitom nemá ani tušení, že v jeho těle probíhá, buď masivní sbírka kyselé organické hmoty vedoucí ke vzniku dalších smetišť, nebo už demontáž prováděná neustále rostoucí armádou změněných symbiontů. Jejich mocné enzymy a metabolizované jedy (také kyselé) zhutňují původní koloidní status hostitele na tuhou fázi (od zhoustnutí krve, přes zhutnění lymfy, k dalším nádorům a následným metastázím). Všichni chronicky nemocní lidé mají patogeny, nízkou energii, nízké vibrace a teplotu, nízké pH vnitřního prostředí, ucpaný lymfatický systém a hustou krev s vysokým pH. Protože krev tělesné pH kompenzuje, její zvýšené pH (přes pH 7.45 – 7.50) odpovídá vnitřnímu prostředí pod pH 5,0 – což znamená anaerobní metabolismus. Tumor má pH 3,5 > 3,0 a sestává z husté pavučiny kyselých, lidských buněk a plísní. Když pH krve vystoupí přes pH 7.8, brzy omdlíme a krátce poté zemřeme. My tento proces sběru kyselé organické hmoty, (který má řadu úrovní a forem) klasifikujeme jako „nemoc“. Ve skutečnosti však jde o normální průběh, při němž Matka příroda zprvu bojuje tím, že vytváří zapouzdřená smetiště s úmyslem zachránit život jak zbylým buňkám tak nám. Je-li však v nás tolik kyselosti a jedů, že nám nemůže udržet život ani vytvářením nádorů, rozebere nás zpět na atomy a recykluje je, pro lepší využití někde jinde. Tak či onak, není třeba se děsit, nebo dokonce nenávidět nějaké mikroorganizmy, či naše symbionty. Ti jsou žijící organizmus jako my, potřebují naši ochranu a prostředí (pH), které jim umožňuje žít. Hostíme-li je přírodní stravou, láskou a mírem v duši, čistí nás, až se leskneme. Hostíme-li je průmyslovou stravou, stresy, nenávistí a zlobou, rozebírají nás. Toť vše, co dělají. Co v nás symbionti dělají ze dne na den, závisí výhradně na pH našeho vnitřního prostředí – a za to si můžeme vždy JEN MY SAMI.

Toto je část zdravé krevní buňky.
Vpravo nahoře je černá šipka, kde jsou sotva viditelné malinké tečky nastřádané jako korálky. Další korálky jsou vpravo, zhruba v polovině krevní buňky a hustější korálky jsou vpravo dole šikmo. To jsou naši hodní symbionti.
Velikost šťastného symbionta je pod 1 Angstrom.
(1 Angstrom je 10 milionkrát menší než 1 milimetr)
(Bílé ostrůvky na kruhové části krvinky, nejsou symbionti, ale albumin)
SHRNUTÍ: Zmíněný 13 stupňový cyklus není nic víc, než odůvodněná reakce na změnu pH, vedoucí k snížení hladiny kyslíku a produkce nezvyklých chemických sloučenin s neobvyklými vibracemi.
také tento postup Matky přírody je známý už lidem věkům a směruje ke každému známému onemocnění, není tato na pH spočívající v představách zdraví a nemoci přijímání současným lékařským proudem – pilulky, ozařování, chemoterapie a chirurgie jsou mnohem výnosnější, než doporučené specifické potraviny a lakmusových papírků , aby se každý mohl uzdravit sám.
Matka příroda však miluje život a nízké pH vnitřního prostředí, nedostatek kyslíku a následný cyklus degradace symbionty, učinila reverzibilní, (pokud ovšem množství smrtících patogenů rozebírajících hostitele už nezískalo drtivou převahu). Je-li vnitřní prostředí těla okamžitě a dokonale život vyčištěno, dodán kyslík a minerály, pH tělesných úrovní úspěšně dosáhnete podporující – pak se smrtících symbiontů změněných v patogeneze, (také VELMI citliví na pH) opět změní velmi užitečné a čistící symbionty. Ti pak začnou pilně pracovat na likvidaci patogenů přivolaných zvenčí, a na opravách všech poškození (včetně likvidace nádorů) vytvořených jejich destruktivními formami, takže hostitel může být během 12-24 měsíců opět zcela zdráv. Bude-li však své tělo opět zaplavovat převahou protonů, spustí stejný 13-stupňový degradační cyklus znovu. Když se úsilí o upravení pH hostitele nezdaří, bude jeho tělo ztuženo kvintilióny jeho vlastních symbiontů. Poněvadž organická hmota po smrti nabude alkalické pH, patogenní formy se opět změní v prospěšné symbionty, opustí hostitele a začnou organizovat nový život někde jinde.
SHRNUTÍ: Všechny představitelné choroby jsou od okamžiku počtu ukryty přímo v nás. Co zdědíme od našich rodičů nejsou jen geny, ale i jejich způsob života, jejich názory, zvyklosti, stravování a hlavně jejich symbionty. Ve vajíčku a spermii jsou vždy dva symbionti, jeden je pozitivní(+) a druhý negativní(-). Naše zdraví po narození bude takový jaký stupeň ze 13 fází symbiontů nám při počtu předali rodiče. Není však nutné propadnout beznaději, neboť každý z nás může časem vytvořit život udržující pH ve svém těle. Symbionti jak rodiče, tak naše, tato výhoda nadšeně přizpůsobí, změní se v nejsilnější systém na světě, a odvděčí se nám tím, že nás bude čistit, čímž my dožijeme dlouhého věku bez nemoci. Vztah kdy dva odlišné organizace získávají výhody, které jsou pro velmi prospěšné, jsou známé jako symbióza.
Všechno, co nám dal k jídlu Bůh má živá semena, která nám podávají svoji energii a život. Potraviny vyráběné člověkem mají mrtvá semena, která nám berou naši energii a život.
Proto vám říkám, nejezte nic, co oheň, mráz, nebo voda zničí! Vaše tělo je to co vaše potraviny jsou, stejně tak je vaše nálada a vaše myšlenky jsou. Spálené, zmražené potraviny a hnilotiny budou ve vás hořet, mrazit a ničit vaše tělo, neboť vše co zabije vaše potraviny, zabije i vaše tělo.
(Poznatek starý přes 2000 let)
Amen.
PONAUČENÍ:
Typ a stupeň onemocnění je vždy v perfektním souladu s pH tekutin ve vašem těle.
Nejrychlejšími spouštěči degradačního cyklu jsou:
- silná dávka ozáření, bílý cukr, veškeré zvířecí proteiny, uměle vytvořené proteiny a uhlohydráty, všechny produkty syntetické chemie (farmaceutika, kosmetika, zemědělství atd.)
K rychlým spouštěčům degradačního cyklu patří:
- mikrovlnné trouby, dlouhodobé stresy, negativní emoce, posttraumatické poruchy alkohol a chemická analýza.
Střední spouštěči degradačního cyklu jsou:
- veškerá uměle zpracovaná jídla, nápoje a farmaceutické výrobky.
Pomalými spouštěči jsou:
- znečištěné životní prostředí, elektro smog a mobilní telefony (slabé ozáření).
Nejrychlejší spouštěči vratného cyklu jsou:
- rychlé a důkladné pročištění těla, ionizovaná voda, sluneční světlo, kyslík, ozón, emitory fotonů, život podporující oscilaci, negativní ionty, zeleninové džusy, kvašené potraviny a živá syrová potrava vyráběná jen Matkou Přírodou.
Nic v tomto článku není zamýšleno jako lékařská rada. Pro lékařskou radu, diagnózu a pomoc navštivte prosím svého lékaře.
Diskuze na toto téma se nachází
